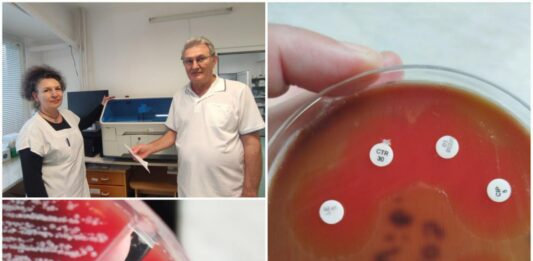
Бактерия човекоядец

Месец борба и 10 операции: Лекари от Бургас спасиха пациентка, заразена с „бактерия човекоядец“
Лекари от УМБАЛ-Бургас успешно спасиха живота на 61-годишна жена, заразена с изключително рядката, но опасна бактерия Вибрио вулнификус, известна като „бактерия човекоядец“. Жената, която пострадала по време на почивка на къмпинг Силистар, влязла в морето с открита рана на крака. В рамките на същия ден кракът ѝ започнал да се подува, появили се мехури и … Продължете с четенето на Месец борба и 10 операции: Лекари от Бургас спасиха пациентка, заразена с „бактерия човекоядец“
2 коментара